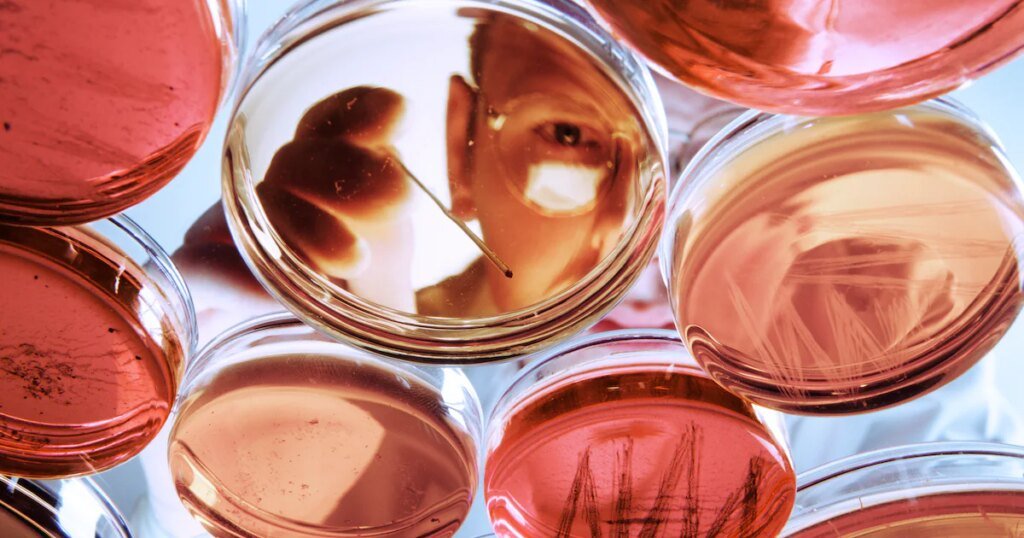
adbf3c33-1f39-4d6a-97dd-d9b2618f9c6a.7350086d-467d-4422-a5ae-d96498b3a654.jpg

El desarrollo de nuevos fármacos es cada vez más caro y, por tanto, lleva más tiempo desarrollarlo. La inteligencia artificial y los miniórganos fabricados a partir de placas de Petri ayudan en la carrera contra el tiempo.
El profesor Carsten Claussen lleva más de 25 años investigando. “El único ingrediente activo que llega a la farmacia es como la proverbial aguja en un pajar”, afirma el director de la sucursal de Hamburgo del Instituto Fraunhofer de Medicina Traslacional y Farmacología ITMP.
Una vez, revela Claussen, casi lo logra. Pero el supuesto medicamento contra el Alzheimer no tuvo ningún efecto en los humanos. “Mi esposa pensaba que íbamos a ser ricos. Lamentablemente tuve que decepcionarla”, recuerda. “Así que me quedaré en Fraunhofer y ¡con mucho gusto!” Después de todo, ya ha logrado mucho.
Detección de alto rendimiento mediante inteligencia artificial
Con mucha perseverancia y conocimientos, Claussen y su equipo examinan bibliotecas de sustancias, que a menudo contienen cientos de miles o más de moléculas, para encontrar un “resultado”. Esto es lo que los expertos describen como un golpe prometedor que puede fijarse en un objetivo activo previamente identificado en el cuerpo, el objetivo, y, por ejemplo, bloquear el crecimiento de células cancerosas.
El equipo lleva a cabo el llamado cribado de alto rendimiento, en el que las moléculas se prueban automáticamente para ver si interactúan con el objetivo y cómo. Claussen: “Por supuesto, no sólo comprobamos las moléculas, sino que intentamos seleccionar de antemano las más relevantes”.
Para ello, los investigadores utilizan los datos existentes sobre las estructuras químicas y las propiedades biológicas de las moléculas, como el metabolismo o la interacción de las proteínas, y entrenan modelos de inteligencia artificial que ayudan a predecir las estructuras ideales de los ingredientes activos: “Esto nos permite delimitar de forma mucho más precisa el grupo de sustancias en cuestión. Nuestra búsqueda se vuelve más rápida, más específica y más inteligente. Las posibilidades de éxito se duplican”.
Descubierto nuevo efecto de una sustancia contra la epilepsia
Su éxito más reciente: descubrieron un compuesto eficaz contra la epilepsia en niños. Encontraron lo que buscaban en la llamada biblioteca de reutilización, una colección de sustancias ya aprobadas para una indicación médica específica. Claussen: “La idea es obvia: un fármaco también puede tener efectos beneficiosos en otras partes del cuerpo”.
La ventaja: los tiempos y costes de desarrollo se reducen porque ya no son necesarias muchas pruebas y se pueden omitir algunas fases de desarrollo. También se pueden eliminar los riesgos relacionados con conexiones previamente desconocidas.
Porque no todos los hits son adecuados como ingrediente activo: la sustancia podría ser tóxica, degradarse rápidamente en el suero sanguíneo o provocar efectos secundarios peligrosos. Esto se determina mediante pruebas exhaustivas en cultivos celulares, en animales y, posteriormente, si todo va bien, también en humanos. Claussen: “Se necesitan entre cinco y siete años antes de que el medicamento pueda administrarse a los primeros sujetos de prueba. Las tasas de fracaso son increíblemente altas”.
El desarrollo cuesta 2.800 millones de dólares por fármaco
Según la Asociación de Empresas Farmacéuticas de Investigación (VFA), de 10.000 sustancias con potencial de eficacia, unas nueve se prueban en humanos y sólo una llega al mercado en un momento posterior.
Por lo tanto, no sorprende que desarrollar un nuevo medicamento sea costoso y requiera mucho tiempo: los costos totales actuales promedian 2.800 millones de dólares. Pasan doce años desde la primera idea hasta su aprobación, culminación actual de una tendencia que se mantiene ininterrumpida desde los años cincuenta.
Una razón importante: los productos farmacéuticos son cada vez más complejos. Si inicialmente los principales objetivos de desarrollo eran enfermedades con mecanismos de acción simples o síntomas generalizados como dolor de cabeza o acidez de estómago, hoy son el cáncer o las enfermedades reumáticas sistémicas. Estos influyen en numerosos procesos biológicos del cuerpo y sólo pueden tratarse eficazmente con terapias combinadas de diferentes principios activos.
Los mecanismos de las enfermedades son complejos y a menudo no se comprenden completamente, lo que dificulta la derivación de objetivos. “La inteligencia artificial también puede ayudarnos mucho en este aspecto”, está convencido Claussen. Esto permite tener en cuenta numerosos parámetros que influyen en la enfermedad, combinarlos entre sí y así identificar objetivos esenciales.
La experimentación con animales ya no es absolutamente necesaria
Una vez que se encuentra un candidato a ingrediente activo prometedor, se prueba su eficacia y seguridad. Ahora es posible en muchos casos ahorrar esfuerzos y largos tiempos de aprobación para experimentos con animales: la Dra. Julia Neubauer, directora del Centro de Proyectos Fraunhofer para Tecnología de Procesos de Células Madre, y su colega el Prof. Florian Groeber-Becker, director del Centro de Traducción Fraunhofer para Terapias Regenerativas, están trabajando juntos en Würzburg en modelos de tejidos innovadores basados en células para pruebas de fármacos.
Además de células primarias de diversos tejidos, como la piel o los ojos, utilizan células madre pluripotentes inducidas o células iPS para obtener células madre cortas creadas artificialmente a partir de las cuales se pueden cultivar diferentes tipos de células. Éstas tienen, entre otras cosas, la ventaja de ser uniformes y reproducibles, mientras que las células primarias pueden variar. Además, algunas células primarias, como las células del músculo cardíaco o las células neuronales, son difíciles de aislar y cultivar.
La alternativa: modelos de prueba humanos de la placa de Petri
Otra gran ventaja de estos modelos de tejidos es que pueden replicar estados o mecanismos de enfermedades específicos.
“Un animal de laboratorio inicialmente no tiene ninguna enfermedad, lo que significa que antes de realizar las pruebas es necesario inducir la patología”, explica Groeber-Becker. Por el contrario, los modelos de tejidos no sólo no plantean problemas éticos, sino que también proporcionan resultados significativamente mejores. Neubauer: “Básicamente pongo al enfermo en la placa de Petri”.
Se necesitan de tres a seis semanas antes de que los modelos de prueba en humanos estén listos para su uso. “En los cardiomiocitos, es decir, en las células del músculo cardíaco, ya después de siete días tenemos pequeños agregados pulsantes que se contraen como pequeños corazones”, afirma satisfecho Neubauer. Luego maduran y se cultivan en determinadas condiciones de tal manera que se crean tejidos tridimensionales, los llamados organoides. Estos corazones modelo, que son aproximadamente del tamaño de la cabeza de un alfiler, se pueden utilizar para probar cómo los fármacos cardíacos innovadores afectan la fuerza de contracción o el ritmo.
También es posible probar diferentes principios activos uno tras otro o combinados en el mismo modelo sin ningún problema. Groeber-Becker: “Con nuestros modelos de piel, que tienen aproximadamente el tamaño de una uña, es posible incluso masajear una formulación, por ejemplo una crema, con un algodón”.
Los patrones de tela tardan mucho más y son más baratos
Los modelos se pueden utilizar durante aproximadamente una o dos semanas, después de lo cual las células son demasiado viejas y pierden gradualmente su funcionalidad. Según Groeber-Becker, todavía no es posible evitar por completo la experimentación con animales en el desarrollo de fármacos. “Pero estamos trabajando para garantizar que cada vez sea menos necesario”.
Groeber-Becker informa que el interés por los modelos de tejidos y organoides es grande porque tienen otra ventaja decisiva: “Se ahorra mucho tiempo y dinero porque nuestros modelos humanos aumentan el poder predictivo. Esto significa que se puede predecir con mucha más precisión cómo se comportará el ingrediente activo en humanos y si vale la pena realizar estudios clínicos”.
Reclutar participantes en el estudio lleva mucho tiempo
Pero incluso si el pronóstico es favorable, sólo algunos de los fármacos candidatos más prometedores terminan en los pacientes. Aún queda por abordar uno de los mayores obstáculos en la investigación de fármacos: reclutar participantes para los ensayos clínicos.
Hasta ahora, la búsqueda de sujetos de prueba se ha realizado principalmente de forma manual. Los empleados de clínicas y consultorios médicos controlan su base de pacientes y la comparan con la lista de requisitos del estudio respectivo, un proceso largo y laborioso que a menudo no tiene éxito: al menos el 20% de todos los ensayos clínicos fracasan porque no se encuentran suficientes candidatos.
La inteligencia artificial apoya la búsqueda en bases de datos de pacientes
Una nueva solución basada en IA, desarrollada en el Instituto Fraunhofer de Sistemas de Información y Análisis Inteligentes IAIS en Sankt Augustin, cerca de Bonn, ofrece una solución. Le permite extraer fácilmente información relevante de textos continuos como historias clínicas o cartas de médicos y compararlos con criterios de inclusión y exclusión de ensayos clínicos. Por ejemplo, puedes buscar en la base de datos de una clínica en segundos. No importa en qué formato de archivo se guarde la información.
“Los modelos de IA actuales pueden manejar datos multimodales, incluidas imágenes o tablas. Actualmente estamos trabajando para integrar dichos modelos en nuestras soluciones”, explica Sina Mackay, científica de datos de Fraunhofer IAIS. La comparación con los catálogos de requisitos de estudios actuales, que se publican en sitios web centrales como el Registro de ensayos clínicos de la UE, podría realizarse automáticamente.
Una aplicación debería facilitar la coincidencia para todos
Pero no es sólo la industria farmacéutica, muchos pacientes también buscan estudios adecuados para ellos, por ejemplo para acceder a terapias innovadoras o para apoyar la investigación médica y así ayudar a otras personas con enfermedades similares.
Para ellos, el equipo de Fraunhofer IAIS trabajó con socios para crear un prototipo de una aplicación que puede comparar datos personales del registro médico electrónico (ePA) con perfiles de requisitos de estudio publicados en sitios web. “La probabilidad de éxito aumenta cuando ambas partes implicadas investigan activamente: los desarrolladores de fármacos y los pacientes”, explica Mackay. Por tanto, el reclutamiento de participantes en el estudio podría ser mucho más rápido, más eficiente y más exitoso.
Antes de que la aplicación DATACARE pueda acceder a la historia clínica electrónica, es necesario, entre otras cosas, aclarar cuestiones legales y garantizar la protección de datos. Mackay: “Además, por supuesto, todos los documentos relevantes deberían estar disponibles en el historial médico electrónico, algo que no podemos asumir por el momento”. Sin embargo, sigue confiada: “Se ha comenzado a hacerlo”.

